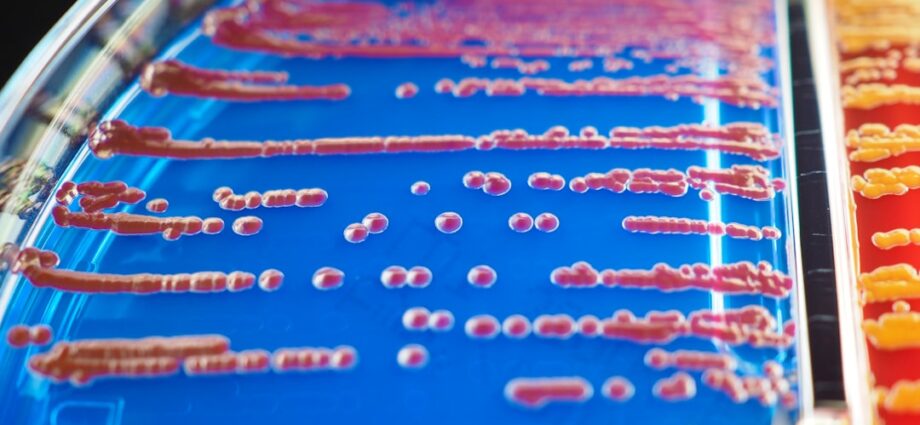
Photo early detection

Depistarea precoce a bolilor joacă un rol esențial în prevenirea complicațiilor grave care pot apărea pe parcursul evoluției unei afecțiuni. Atunci când o boală este identificată în stadii incipiente, șansele de tratament eficient cresc semnificativ. De exemplu, în cazul cancerului, diagnosticarea timpurie poate face diferența dintre o intervenție chirurgicală simplă și un tratament complex, cu multiple efecte adverse.
Astfel, depistarea precoce nu doar că îmbunătățește prognosticul pacientului, dar și calitatea vieții acestuia.
Pe lângă aspectele medicale, depistarea timpurie a bolilor are și un impact social considerabil. O comunitate în care bolile sunt identificate rapid va avea o populație mai sănătoasă, ceea ce se traduce printr-o reducere a absenteismului la locul de muncă și o creștere a productivităț În plus, prevenirea complicațiilor reduce povara asupra sistemului de sănătate, permițând alocarea resurselor către alte nevoi urgente.
Importanța depistării precoce a afecțiunilor medicale este un subiect esențial în domeniul sănătății, iar un articol relevant care abordează acest aspect este disponibil la acest link. Acesta discută despre importanța conștientizării și educației în prevenirea bolilor, subliniind rolul crucial al diagnosticării timpurii în îmbunătățirea calității vieții pacienților.
Rezumat
- Depistarea precoce a bolilor este crucială pentru prevenirea complicațiilor și îmbunătățirea prognosticului pacienților.
- Diverse boli pot fi depistate precoce prin intermediul testelor de screening, examinărilor medicale regulate și analizelor de laborator.
- Screening-ul medical joacă un rol esențial în identificarea precoce a bolilor, oferind posibilitatea de intervenție timpurie și tratament adecvat.
- Depistarea precoce a bolilor are un impact semnificativ asupra eficacității tratamentului și procesului de recuperare al pacienților.
- Pacienții beneficiază de depistarea precoce a bolilor prin posibilitatea de a beneficia de tratament prompt și de a evita complicațiile grave.
- Consultul medical regulat este de o importanță crucială în depistarea precoce a bolilor și menținerea stării de sănătate a pacienților.
- Depistarea precoce a bolilor poate influența semnificativ calitatea vieții, oferind posibilitatea de tratament și gestionare a afecțiunilor în stadii incipiente.
- Educația și conștientizarea sunt esențiale în promovarea depistării precoce a bolilor, contribuind la creșterea gradului de conștientizare și implicare a populației.
- Depistarea precoce a bolilor are un impact pozitiv în reducerea costurilor de tratament, evitând complicațiile și stadiile avansate ale bolilor.
- Depistarea precoce a bolilor poate contribui semnificativ la prelungirea vieții prin intervenție timpurie și gestionare adecvată a afecțiunilor.
- Strategiile pentru promovarea depistării precoce a bolilor în comunitate includ campanii de informare, programe de screening și acces facil la servicii medicale.
Cum pot fi depistate precoce diverse boli
Există mai multe metode prin care bolile pot fi depistate precoce, iar acestea variază în funcție de tipul de afecțiune. Examinările medicale regulate, analizele de sânge și testele de screening sunt doar câteva dintre instrumentele disponibile pentru identificarea timpurie a bolilor. De exemplu, mamografiile sunt recomandate femeilor pentru depistarea cancerului de sân, iar testele de PSA sunt utilizate pentru a evalua riscul de cancer de prostată la bărbaț Aceste metode sunt esențiale pentru a asigura o intervenție rapidă și eficientă.
Pe lângă testele specifice, educația pacienților joacă un rol crucial în depistarea precoce a bolilor. Conștientizarea simptomelor și a factorilor de risc poate determina indivizii să solicite ajutor medical mai devreme. De exemplu, cunoașterea semnelor timpurii ale diabetului sau ale bolilor cardiovasculare poate încuraja pacienții să se prezinte la medic înainte ca afecțiunile să devină severe.
Rolul screening-ului medical în depistarea precoce a bolilor

Screening-ul medical reprezintă o metodă sistematică de identificare a bolilor înainte ca simptomele să devină evidente. Această abordare proactivă permite detectarea unor afecțiuni care, altfel, ar putea rămâne nediagnosticate până în stadii avansate. De exemplu, screening-ul pentru hipertensiune arterială sau colesterol ridicat poate ajuta la prevenirea bolilor cardiovasculare prin intervenții timpurii.
Un alt aspect important al screening-ului este că acesta poate fi realizat la scară largă, ceea ce îl face accesibil unui număr mare de persoane. Campaniile de screening organizate în comunități sau prin intermediul instituțiilor medicale pot contribui la creșterea ratei de depistare precoce a bolilor. Astfel, screening-ul nu doar că ajută la identificarea pacienților cu risc, dar și la educarea populației cu privire la importanța sănătății preventive.
Impactul depistării precoce a bolilor asupra tratamentului și recuperării

Depistarea precoce a bolilor are un impact semnificativ asupra opțiunilor de tratament disponibile pentru pacienț Atunci când o boală este diagnosticată devreme, medicii pot recomanda tratamente mai puțin invazive și mai eficiente. De exemplu, în cazul cancerului, intervențiile chirurgicale pot fi mai puțin complexe și pot necesita o recuperare mai rapidă. Aceasta nu doar că îmbunătățește prognosticul pacientului, dar și calitatea vieții acestuia pe termen lung.
Recuperarea după un tratament este, de asemenea, influențată de momentul în care boala a fost depistată. Pacienții care beneficiază de un diagnostic timpuriu au șanse mai mari să se recupereze complet și să revină la activitățile lor obișnuite într-un interval mai scurt. Aceasta subliniază importanța nu doar a tratamentului în sine, ci și a momentului în care acesta este inițiat.
Importanța depistării precoce a afecțiunilor ORL este esențială pentru a asigura un tratament eficient și pentru a preveni complicațiile ulterioare. Un articol relevant pe această temă poate fi găsit aici, unde sunt prezentate informații utile despre serviciile oferite de cabinetele ORL din Suceava, inclusiv importanța consultului de specialitate în timp util. Astfel, conștientizarea și accesul rapid la servicii medicale pot face o diferență semnificativă în sănătatea pacienților.
Beneficiile depistării precoce a bolilor pentru pacienți
| Metrică | Valoare |
|---|---|
| Rata de supraviețuire | Îmbunătățirea șanselor de vindecare |
| Costuri medicale | Reduse prin tratamentul timpuriu |
| Impactul social | Reducerea impactului asupra familiei și comunității |
Beneficiile depistării precoce a bolilor pentru pacienți sunt multiple și variate. În primul rând, identificarea timpurie a unei afecțiuni permite pacienților să ia măsuri proactive pentru a-și gestiona sănătatea. Aceasta le oferă oportunitatea de a se implica activ în procesul lor de tratament și recuperare, ceea ce poate duce la o stare generală mai bună de sănătate.
În plus, pacienții care beneficiază de un diagnostic timpuriu au adesea acces la opțiuni terapeutice mai variate. Aceasta le permite să aleagă tratamente care se potrivesc cel mai bine nevoilor lor individuale și stilului de viață. De asemenea, depistarea precoce poate reduce anxietatea asociată cu incertitudinea legată de starea de sănătate, oferind pacienților un sentiment de control asupra situației lor.
Importanța consultului medical regulat în depistarea precoce a bolilor
Consultul medical regulat este esențial pentru depistarea precoce a bolilor. Multe afecțiuni nu prezintă simptome evidente în stadii incipiente, ceea ce face ca vizitele periodice la medic să fie cruciale. Aceste întâlniri permit medicilor să monitorizeze sănătatea pacienților și să efectueze teste necesare pentru identificarea eventualelor probleme.
De asemenea, consulturile regulate contribuie la creșterea conștientizării pacienților cu privire la importanța sănătății preventive. Medicul poate oferi informații despre stilul de viață sănătos și despre factorii de risc specifici fiecărui pacient. Astfel, pacienții devin mai responsabili în ceea ce privește propria sănătate și sunt mai predispuși să solicite ajutor medical atunci când este necesar.
Cum poate depistarea precoce a bolilor să influențeze calitatea vieții
Depistarea precoce a bolilor are un impact direct asupra calității vieții pacienților. Atunci când o boală este identificată devreme, pacienții au șanse mai mari să beneficieze de tratamente eficiente care le permit să își continue activitățile zilnice fără întreruperi semnificative. Aceasta le oferă oportunitatea de a menține relațiile sociale și profesionale intacte, contribuind astfel la o viață echilibrată și satisfăcătoare.
În plus, pacienții care primesc un diagnostic timpuriu au adesea o stare mentală mai bună. Anxietatea și stresul asociate cu incertitudinea legată de sănătate pot fi reduse semnificativ atunci când persoanele știu că au fost supuse unor evaluări medicale adecvate și că au acces la tratamente eficiente. Aceasta subliniază importanța nu doar a sănătății fizice, ci și a celei mentale în contextul depistării precoce a bolilor.
Rolul educației și conștientizării în promovarea depistării precoce a bolilor
Educația și conștientizarea sunt fundamentale în promovarea depistării precoce a bolilor. Campaniile de informare pot ajuta populația să înțeleagă importanța controalelor medicale regulate și să recunoască semnele timpurii ale diverselor afecțiuni. Aceste inițiative pot fi desfășurate prin intermediul școlilor, comunităților sau instituțiilor medicale.
De asemenea, educația continuă pentru profesioniștii din domeniul sănătății este esențială pentru asigurarea unei evaluări corecte și rapide a pacienților. Medici bine informați pot oferi sfaturi adecvate și pot recomanda teste specifice care să ajute la identificarea timpurie a bolilor. Astfel, conștientizarea devine un instrument puternic în lupta împotriva afecțiunilor grave.
Importanța depistării precoce a bolilor în reducerea costurilor de tratament
Depistarea precoce a bolilor nu doar că îmbunătățește prognosticul pacienților, dar contribuie și la reducerea costurilor asociate cu tratamentele medicale. Atunci când o boală este identificată devreme, intervențiile necesare sunt adesea mai puțin costisitoare decât cele necesare în stadii avansate ale afecțiunii. De exemplu, tratamentele pentru cancer pot deveni extrem de costisitoare dacă boala este diagnosticată târziu.
Reducerea costurilor nu se referă doar la cheltuielile directe legate de tratament; aceasta include și economiile realizate prin evitarea spitalizărilor frecvente sau a complicațiilor severe care necesită intervenții complexe. Astfel, depistarea precoce nu doar că protejează sănătatea pacienților, dar contribuie și la sustenabilitatea sistemului de sănătate.
Cum poate depistarea precoce a bolilor să contribuie la prelungirea vieții
Un alt beneficiu semnificativ al depistării precoce a bolilor este capacitatea sa de a contribui la prelungirea vieții pacienților. Studiile arată că persoanele care beneficiază de un diagnostic timpuriu au șanse mult mai mari să supraviețuiască unor afecțiuni grave comparativ cu cei care sunt diagnosticați tardiv. Aceasta se datorează faptului că intervențiile rapide permit controlul eficient al bolii și reduc riscul apariției complicațiilor severe.
În plus, prelungirea vieții nu se referă doar la numărul de ani trăiți, ci și la calitatea acestor ani. Pacienții care primesc un diagnostic timpuriu au adesea o viață activă și împlinită, având posibilitatea de a se bucura de momente importante alături de cei dragi.
Strategii pentru promovarea depistării precoce a bolilor în comunitate
Promovarea depistării precoce a bolilor în comunitate necesită implementarea unor strategii eficiente care să ajungă la un număr cât mai mare de persoane. Organizarea de campanii de informare și educație despre importanța controalelor medicale regulate este esențială. Aceste campanii pot include sesiuni informative în școli, centre comunitare sau locuri de muncă.
De asemenea, colaborarea cu instituțiile medicale locale pentru organizarea unor zile dedicate screening-ului gratuit poate atrage atenția asupra importanței depistării precoce. Aceste inițiative nu doar că facilitează accesul la servicii medicale, dar contribuie și la creșterea conștientizării cu privire la sănătatea preventivă în rândul populației. Astfel, comunitățile pot deveni mai sănătoase și mai informate, reducând riscurile asociate cu afecțiunile grave prin intervenții timpurii.
FAQs
Care este importanța depistării precoce a unei afecțiuni?
Depistarea precoce a unei afecțiuni poate duce la un tratament mai eficient și la o recuperare mai rapidă a pacientului. De asemenea, depistarea precoce poate preveni complicațiile și consecințele grave ale unei afecțiuni netratate.
De ce este important să facem screening-uri regulate pentru diverse afecțiuni?
Screening-urile regulate pot ajuta la depistarea precoce a unor afecțiuni care pot fi asimptomatice în stadiile incipiente. Acest lucru poate crește șansele de tratament eficient și de recuperare completă.
Care sunt unele exemple de afecțiuni pentru care depistarea precoce este crucială?
Unele exemple de afecțiuni pentru care depistarea precoce este crucială includ cancerul, diabetul, bolile de inimă, hipertensiunea arterială, precum și afecțiunile psihice precum depresia și anxietatea.
Cum pot contribui medicii la depistarea precoce a afecțiunilor?
Medicii pot contribui la depistarea precoce a afecțiunilor prin promovarea screening-urilor regulate, educarea pacienților cu privire la semnele și simptomele de alarmă ale diferitelor afecțiuni, și prin efectuarea examenelor medicale preventive.
Ce măsuri pot lua persoanele pentru a-și depista precoce afecțiunile?
Persoanele pot lua măsuri pentru a-și depista precoce afecțiunile prin efectuarea screening-urilor recomandate de către medici, prin adoptarea unui stil de viață sănătos, și prin acordarea atenției necesare semnelor și simptomelor care ar putea indica prezența unei afecțiuni.